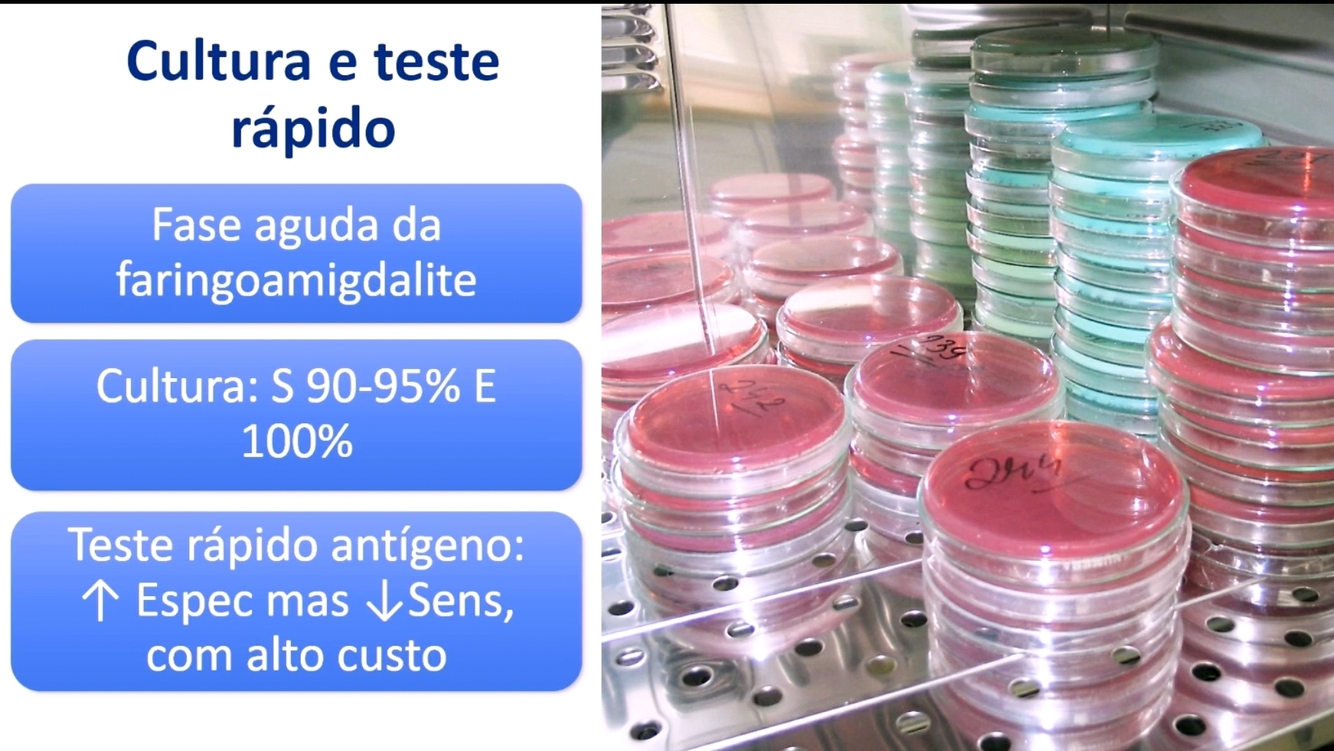

O q causa febre reumática?

Febre reumática tem algum componente genético?

Qual a base genética da Febre reumática?

Quais as fases da Febre reumática?

Qual a idade em que pode ocorre a Febre reumática aguda?

Quais são as principais caracteristicas da faringoamigdalite que pode levar a FR?
Estreptococus beta hemolitico do grupo A

Qual o intervalo entre o quadro de amigdalite e febre reumática aguda?
Período médio de 2 semanas

O quadro de FR aguda pode ser concomitante a faringoamigdalite?
Nao

Quais as manifestações clínicas da febre reumática?

Qual a principal sequela da febre reumática?

Como é o diagnóstico de febre reumática?

O que é o ASLO?
É um marcador imunológico que significa que vc teve contato com uma estreptococcus, não necessariamaente reumatológico

O que teve de mudança na revisão dos critérios de Jones?

O que define ser baixo ou alto risco?

Quais são os critérios de Jones (em populações de alto e baixo risco)?
Quais os critérios menores de Jones?

Quais os critérios maiores de Jones?

Qual a importancia do ECO na FR?

Quais as características da cultura e TR para FR?
Quando surge o ASLO? Todo paciente com FR tem ASLO positivo?

Quando surge o ASLO? Todo paciente com FR tem ASLO positivo?

Quais outros anticorpos anti estreptococcus podem ser usados além do ASLO?

Febre reumática sempre tem ASLO positivo?

Quais as alterações ao RX de tórax encontradas na FR?

Quais alterações podem surgir no ECG na FR?









































































